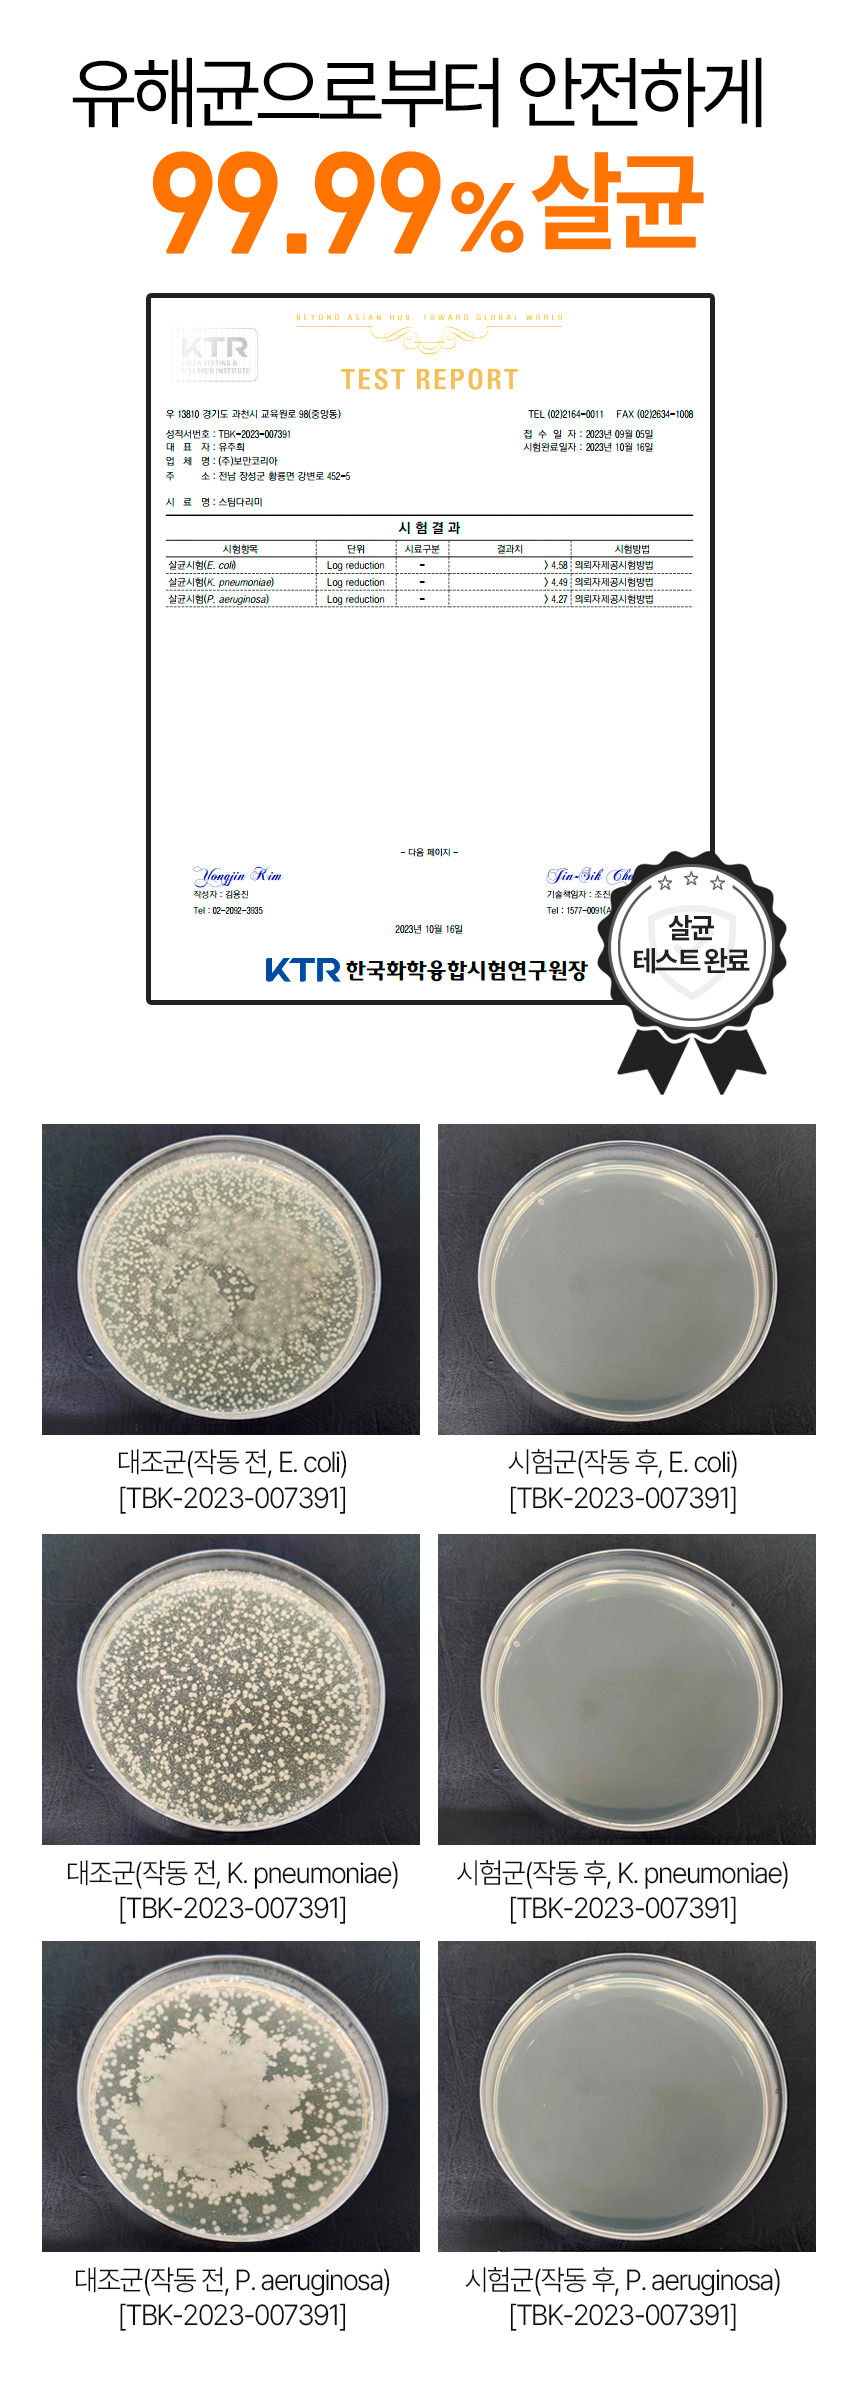

今日の為替レート
お振込銀行
クレジットカード支払い
ログイン | LOGIN
商品カテゴリー
- ブランドファッション
- ファッション/雑貨
- ビューティー
- 食品
- 出産/育児
- 生活雑貨
- パソコン
- レジャー
보만 미니스팀다리미 스탠드형 핸디형 스팀다리미 휴대용 여행용
|
|||||||||||||||||
| 商品購入についてのご案内 | |||
|
|||
본구성























































































|
|||||||||||||||||
| 商品購入についてのご案内 | |||
|
|||